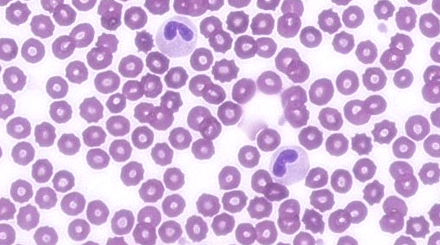

Clot busting: Feline aortic thromboembolism
This webinar will cover the diagnosis and management of feline aortic thromboembolism. Not all owners will want to treat cats that present with this disease, but which cats have a…
Coagulation Disorders ‘If you prick us, do we not bleed?’
In this webinar, we look at the approach to coagulation disorders in small animal practice. Coagulation is complex, but the investigations of these conditions does not have to be. We…
Cobalamin… to be or not to be?
Disorders of cobalamin (vitamin B12) metabolism are increasingly recognized in small animal medicine and have a variety of causes ranging from chronic gastrointestinal disease to hereditary defects in cobalamin metabolism….
Commonly encountered pediatric maxillofacial pathologies in dogs
The field of dentistry is rapidly evolving. This lecture will guide you through the most common paediatric dental and maxillofacial pathologies. Most of these conditions can be diagnosed by the…
Complications in anaesthesia – Avoidance and trouble shooting
Anaesthesia is a routine yet high-stakes aspect of veterinary medicine, where even minor complications can have serious consequences if not anticipated or managed effectively. This practical and informative webinar will…
Cracking the Case of Anaemia – Diagnosis, IMHA, and Transfusion Therapy in Small Animal Practice
Anaemia is a common yet often complex presentation in small animal medicine. This session provides a structured approach to diagnosing and managing anaemia in dogs and cats, combining practical in-clinic…
Cracking the Case of the Itchy Cat: A Practical Approach to Feline Pruritus
Feline pruritus can be one of the most frustrating and nuanced challenges in veterinary dermatology. This focused and practical webinar offers an up-to-date overview of how to confidently manage the…
Culture, Communication and Conflict in veterinary practice
In today’s dynamic veterinary environment, success depends not only on clinical expertise but also on the strength of the team and the culture that supports it. This webinar explores the…
Cytology Reading Sessions ‘Fluid cytology’ (22/08/22)
Our cytology reading sessions are a great way for our Specialists to bring interesting cases for discussion with our vtx community. In this session, the theme of the cytology reading…
Cytology Reading Sessions ‘Fluid cytology 2.0’ (18/12/23)
Our cytology reading sessions are a great way for our Specialists to bring interesting cases for discussion with our vtx community. In this session, the theme of the cytology reading…
Cytology Reading Sessions ‘Fluid cytology 3.0’ (05/06/25)
Our cytology reading sessions are a great way for our Specialists to bring interesting cases for discussion with our vtx community. In this session, the theme of the cytology reading…
Cytology Reading Sessions ‘Haematology’ (29/02/23)
Our cytology reading sessions are a great way for our Specialists to bring interesting cases for discussion with our vtx community. In this session, the theme of the cytology reading…
Cytology Reading Sessions ‘Haematology 3.0’ (11/09/23)
Our cytology reading sessions are a great way for our Specialists to bring interesting cases for discussion with our vtx community. In this session, the theme of the cytology reading…
Cytology Reading Sessions ‘Haematology 4.0’ (05/12/24)
Our cytology reading sessions are a great way for our Specialists to bring interesting cases for discussion with our vtx community. In this session, the theme of the cytology reading…
Cytology Reading Sessions ‘Haematology 5.0’ (19/03/26)
Our cytology reading sessions are a great way for our Specialists to bring interesting cases for discussion with our vtx community. In this session, the theme of the cytology reading…
Cytology Reading Sessions ‘Liver’ (26/06/23)
Our cytology reading sessions are a great way for our Specialists to bring interesting cases for discussion with our vtx community. In this session, the theme of the cytology reading…
Cytology Reading Sessions ‘Lymph nodes’ (23/05/22)
Our cytology reading sessions are a great way for our Specialists to bring interesting cases for discussion with our vtx community. In this session, the theme of the cytology reading…
Cytology Reading Sessions ‘Lymph nodes 2.0’ (24/06/24)
Our cytology reading sessions are a great way for our Specialists to bring interesting cases for discussion with our vtx community. In this session, the theme of the cytology reading…
Cytology Reading Sessions ‘Skin cytology’ (28/11/22)
Our cytology reading sessions are a great way for our Specialists to bring interesting cases for discussion with our vtx community. In this session, the theme of the cytology reading…
Cytology Reading Sessions ‘Skin cytology 2.0’ (06/03/25)
Our cytology reading sessions are a great way for our Specialists to bring interesting cases for discussion with our vtx community. In this session, the theme of the cytology reading…